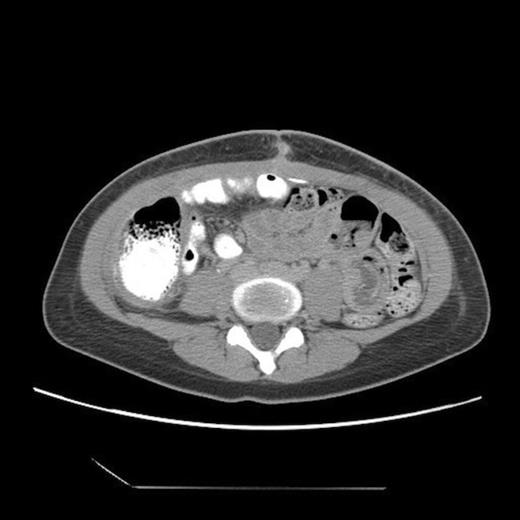
Post-operative abdominal CT demonstrating complete resolution of the fluid compartment

-
PDF
- Split View
-
Views
-
Cite
Cite
BH Wang, L Hasadsri, H Wang, Abdominal cerebrospinal fluid pseudocyst mimicking full-term pregnancy, Journal of Surgical Case Reports, Volume 2012, Issue 7, July 2012, Page 6, https://doi.org/10.1093/jscr/2012.7.6
Close - Share Icon Share
Abstract
Abdominal cerebrospinal fluid pseudocysts (APC) are a relatively uncommon complication of ventriculoperitoneal (VP) shunts, and most frequently occur in the pediatric population. Pediatric patients most often present with neurological sequelae, however, adults may present with abdominal complaints. Here we report a case of a nineteen year-old female with a VP shunt who presented with only abdominal distension suggestive of a full-term pregnancy. Abdominal CT studies subsequently established a diagnosis of APC. A total of 12.7L of fluid was drained laparoscopically, and the VP shunt was eventually revised into a ventriculo-atrial shunt. Because adult patients often present years after their VP shunt procedures with only abdominal complaints, the diagnosis of APC relies on detailed history taking and a strong clinical suspicion. The aetiology, presentation, diagnosis and treatment of APC are also reviewed.
INTRODUCTION
Cerebrospinal fluid (CSF) diversions for the treatment of hydrocephalus are among the most common neurosurgical procedures worldwide. The ventriculoperitoneal (VP) shunt remains the most popular and successful CSF diversion procedure due to the low rate of severe complications. However, the treatment of hydrocephalus has evolved to include a variety of other distal diversion sites, including the right atrium of the heart, ureter, gallbladder, and pleural space.
Abdominal CSF pseudocysts (APC) are a relatively uncommon complication of VP shunts, with a reported occurrence of 0.7% – 4.5% (1,2). The complete lack of mesothelial lining classifies them as pseudocysts (3). Although pediatric patients may often present with headaches, nausea and vomiting, adult patients with APC typically present with abdominal symptoms rather than neurological complaints (2). Such symptoms may include distension, pain, or focal mass. In addition, these patients may present with abdominal complaints years after their shunt procedures. Therefore, primary care physicians, OB/GYNs and general surgeons, rather than neurosurgeons, will often be called for the initial evaluation. Here we report a case of a nineteen-year-old female who presented with only abdominal distension suggestive of a full-term pregnancy. She was subsequently diagnosed with APC and successfully treated. We also review the aetiology, presentation, diagnosis, and treatment of APC.
CASE REPORT
The patient was a nineteen-year-old white female who had a VP shunt placed for congenital hydrocephalus when she was seven days old. She subsequently underwent two revisions, the last of which was performed twelve years ago. For the past several months, she complained of weight gain and progressive abdominal enlargement to the extent that her family and friends were concerned that she was pregnant. However, the patient had not been sexually active and was furthermore on progesterone injections for contraception. Believing that the progesterone may have resulted in her weight gain and abdominal distension, she subsequently discontinued the injections but her abdomen continued to enlarge. She denied any additional symptoms such as headaches, nausea, vomiting, fever, or chills.

Lateral abdominal scout image for CT demonstrating significant abdominal distension

Abdominal CT, axial view, demonstrating a large fluid compartment surrounding the VP shunt catheter resulting in mass-effect, hydronephrosis, and displacement of the intra-abdominal contents
She eventually sought medical attention when she began developing diffuse, unremitting bilateral lower quadrant pain as her abdomen continued to enlarge (Fig. 1). A urine pregnancy test on admission was negative. Abdominal CT demonstrated a large fluid compartment surrounding the VP shunt catheter resulting in mass-effect, hydronephrosis, and displacement of the intra-abdominal contents (Fig. 2 and 3), establishing a diagnosis of APC.

Post-operative abdominal CT demonstrating complete resolution of the fluid compartment
The patient underwent laparoscopic cyst drainage with removal of the cyst wall. A total of 12.7L of fluid was drained. Culture results and routine labs were all negative. A post-operative CT demonstrated complete resolution of the fluid compartment (Fig. 4). The VP shunt catheter was initially left in the abdominal cavity. One month later, however, she developed significant recurrence of fluid collection (Fig. 5) and lethargy from malfunction of the VP shunt. The recurrent fluid was drained under ultrasound guidance, and her abdominal shunt catheter was removed. A new shunt catheter was placed in the right atrium, and the patient made a full recovery without any further complications.

One-month follow up abdominal CT demonstrating recurrent formation of abdominal pseudocyst
DISCUSSION
VP shunt placement may result in a number of potential abdominal complications, including infection, bowel obstruction, volvulus, ileus, and perforation from direct catheter erosion into the gallbladder or bowel. Abdominal peritoneal pseudocysts (APC) are a relatively uncommon complication of VP shunts, with occurring in less than 5% of cases according to previously published reports (1,2). Although the aetiology of APC remains elusive, the consistent histological presence of inflammatory cells in the pseudocyst wall suggests that APC result from a reaction of intraperitoneal structures to either the presence of the catheter or the CSF. Liver dysfunction (4) and hardware infection (5) have also been suggested in the pathogenesis of APC. The clinical presentations of APC vary significantly between pediatric and adult patients (2). In pediatric patients, neurological symptoms derived from shunt malfunction, such as headache, lethargy, nausea and vomiting are the most common initial complaints. These abdominal complaints often occur many years after their VP shunts have been placed. Therefore, they may initially be seen in the setting of primary care.
The diagnosis of APC relies on detailed history taking and a strong clinical suspicion. Abdominal ultrasound and CT are the two principle diagnostic imaging techniques (6). The main imaging criteria for the diagnosis of APC include the presence of an intraperitoneal fluid collection with well-defined margins, generally without internal septa, and the identification of the distal tip of the shunt catheter within or near the pseudocyst. Although ultrasound is as accurate as CT in the diagnosis of APC, it is not as effective as CT in evaluating appendicitis, diverticulitis, and other cystic abdominal lesions, such as cystic ovarian neoplasms, lymphocoeles, mesenteric cysts, cystic mesotheliomas, and pancreatic pseudocysts.
APC is most frequently managed via laparotomic or laparoscopic-assisted fluid drainage with or without wide excision of the APC walls (7). Because the successful reinsertion of the shunt catheter into the peritoneum without recurrence of APC or shunt malfunction has ranges as high as 60-78% (8,9), it is reasonable to re-position the shunt catheter back into the peritoneal cavity after surgical intervention in the abdomen. However, the formation of APC does raise concerns regarding the long-term suitability of the peritoneal cavity as a CSF diversion site. Close clinical and radiographic follow ups for recurrent APC or shunt malfunction are thus mandatory. In many reports, CSF had to be eventually diverted to other cavities due to either APC recurrence or malfunction of the shunt (4,10).